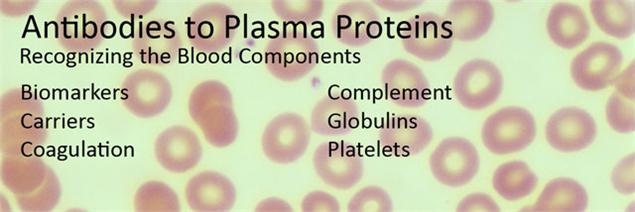
新闻图片2

Specific Tools for Hematology and Plasma Research
Blood proteomics has become increasingly powerful in disease diagnosis, therapeutic monitoring, and clinical chemistry. ABBIOTEC offers over 200 antibodies to human plasma proteins. These antibodies are suitable for the quantitative analysis of physiologically significant mammalian proteins, including biomarkers for disease and cell-specific antigens. Check our website for fluorochrome- and enzyme- conjugated formats available for ELISA, Western blot, immunohistochemistry, flow cytometry and immunofluorescence applications.
BIOMARKERS Bone Gla Protein, CD71, CEA, hCG, CRP, LHRH, LSH, NGAL, PAPP-A, PHM, VIP
CARRIERS Albumin, Alpha-fetoprotein, Apolipoproteins, Butyrylcholinesterase,
Gc-Globulin, Gelsolin, Haptoglobin, Hemoglobin, Hemopexin,
Lactotransferrin, LDL, Ovalbumin, Transthyretin
COAGULATION Alpha-1 Antitrypsin, Annexin V, Antichymotrypsin, Antithrombin III, D-dimer,
Factor VIII, Factor IX, Fibrinogen, Hirudin, Protein C, Protein S,
Prothrombin, Tetranectin, Thrombin, Vitronectin, VWF
COMPLEMENT C1s, C1 Inh, C2, C3, C3a, C4, C5a, C5b-9, C9, CD235a, Factor B, Factor D,
Factor H, Factor I, Ficolin, Mannan-binding Lectin, Properdin
GLOBULINS Gc-globulin, IgA, IgE, IgG, IgM, Kappa, Lambda, Beta2-Macroglobulin
PLATELETS CD9, CD31, CD36, CD41, CD42b, CD61, CD62P, EPO, PDGF-A, PDGF-B, PDGF-C
RECOMBINANT CRP, Cytokeratin-18, Eotaxin, FGF, Fractalkine, GRO-alpha, Haptoglobin, IL-8,
PROTEINS LP-PLA2, NGAL, PAI-1, PDGF, PKM2, TARC, THPO, Tissue Factor
PEPTIDES AGDV, Eptifibatide, Fibrinogen binding, Fibrinogen g-chain dodecapeptide, Fibrinolysis inhibiting factor, Fibrinopeptide, Heparin-binding, RGD and derivatives, Thrombin receptor agonist
Contact our Customer Service Dept for comprehensive product listing and availability.
HAPPY THANKSGIVING TO OUR AMERICAN READERS !!!!

SPECIAL OFFER FOR OUR SUBSCRIBERS - Until December 31, 2015 - Buy 1 antibody, get 2nd at 50% off. Use promo code ENEWS1115 at time of order. Terms and conditions apply.
PRODUCT CITATIONS - For a comprehensive list of product citations, refer to the citation webpage.
Cat. No. 250121 C3 Complement Antibody
Lindblom RP et al. 2014. J Immunol. PMID 24353269. Unbiased expression mapping identifies a link between the complement and cholinergic systems in the rat central nervous system.
Cat. No. 250205 Human IgE
Sharquie I et al. 2013. BMC Immunol. PMID 24330349. An investigation into IgE-facilitated allergen recognition and presentation by human dendritic cells.

Cat. No. 250337 Ovalbumin Chicken (8C6) Antibody
Yang Q et al. 2013. J Biol Chem. PMID 23589293. Antigen-specific immunotherapy regulates B cell activities in the intestine.
Cat. No. 250563 BrdU Antibody for IHC in mouse tracheal epithelium
Hsu H-S et al. 2014. PMID 24280717. Repair of naphtalene-induced acute tracheal injury by basal cell depends on beta-catenin.
Cat. No. 250590 CD31 Antibody
Di Bernardini et al. 2014. J Biol Chem. PMID 24356956. Endothelial lineage differentiation from induced pluripotent stem cells is regulated by microRNA-21 and transforming growth factor beta2 pathways.

Cat. No. 250594 CD68 Antibody for IHC and IF in mouse aortic tissue
Muller I et al. 2013. J Biol Chem. PMID 24003215. Gremlin-1 is an inhibitor of macrophage migration inhibitory factor and attenuates atherosclerotic plaque growth in ApoE-/- mice.

Cat. No. 350365 RGDS Peptide and 350367 RGES Peptide for inhibitory effects on human platelets
Brzoska T et al. 2013. PLOS. PMID 23383331. Binding of thrombin-activated platelets to a fibrin scaffold through alpha-IIb/beta-3 evokes phosphatidylserine exposure on their cell surface.

ABBIOTEC is a biotech company founded in 2007 in San Diego, California, a renowned world-class Life Sciences cluster that hosts more than 1,500 research labs and biotech companies. We are focused on developing, producing and commercializing next generation antibodies and unique reagents for the Life Sciences research community including the diagnostic and pharmaceutical markets.
ABBIOTEC offers years of expertise making antibodies and assay kits for catalog products to the scientific and biotech community. With our recently upgraded animal facility, we offer polyclonal antibody production in small and large animals (rabbits, goats, llama) as well as monoclonal antibody production (mice and rats). Because peptide chemistry is an essential tool to biology, we offercustom peptide synthesis services for research grade peptides.
.
FOLLOW US ON LINKEDIN - ABBIOTEC has a new LinkedIn page. Get the latest news from the scientific community, discover our products and services and look for job opportunities!
|
|
|
|